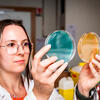
SCANDALEUX : Ce que la science a ÉTONNAMMENT oublié sur la santé des femmes ! La vérité qui va VOUS RÉVOLTER... et la tech qui promet d'ENFIN tout changer !

À l’approche de la Journée internationale des droits des femmes, une réalité glaçante refait surface : la santé des femmes demeure un angle mort colossal de la recherche biomédicale. Pendant des décennies, le corps féminin a été ignoré, sous-étudié, ou pire, traité comme une simple variation du modèle masculin, engendrant des inégalités de genre profondes et des conséquences dramatiques pour des millions de patientes à travers le monde.
Un héritage historique lourd : l’homme comme « standard »
L’histoire de la médecine est intrinsèquement liée à un biais de genre persistant : celui de l’homme comme référence universelle. Pendant des siècles, les essais cliniques, la recherche fondamentale et même l’enseignement médical se sont focalisés sur le corps masculin, considérant les spécificités féminines (hormonales, métaboliques, physiologiques) comme des « complications » ou des exceptions. Ce paradigme a eu des répercussions désastreuses, allant du diagnostic tardif de maladies chez les femmes à la prescription de posologies inadaptées, causant parfois des effets secondaires graves. Des affections comme les maladies cardiovasculaires, souvent perçues comme masculines, se manifestent différemment chez les femmes et sont moins bien diagnostiquées, avec des signes avant-coureurs atypiques fréquemment ignorés par des professionnels de santé non formés à ces spécificités.
Des chiffres alarmants et des conséquences concrètes pour les patientes
Les conséquences de cette négligence sont aujourd’hui quantifiables et alarmantes. Les femmes sont souvent plus longtemps en errance diagnostique pour des maladies auto-immunes, neurologiques ou des douleurs chroniques. Par exemple, une femme victime d’un accident vasculaire cérébral (AVC) peut présenter des symptômes moins évidents que l’homme, ce qui retarde la prise en charge et aggrave le pronostic. De nombreux médicaments, testés majoritairement sur des hommes, montrent des efficacités et des effets secondaires différents chez les femmes, en raison de variations métaboliques et hormonales. Une étude récente a même montré que certains diagnostics de maladies mentales peuvent être faussés par des préjugés de genre, attribuant plus facilement des symptômes physiques à une cause psychologique chez les femmes. Cette situation entraîne non seulement une souffrance accrue, mais aussi un coût sociétal considérable en termes d’absentéisme, de perte de productivité et de dépenses de santé.
La France et l’Europe face au défi : des initiatives émergentes
Conscients de l’ampleur du problème, la France et l’Europe commencent enfin à bouger. Des agences nationales comme l’ANSM (Agence Nationale de Sécurité du Médicament et des produits de santé) et des institutions européennes incitent désormais à l’inclusion systématique des deux sexes dans les essais cliniques et à une analyse différenciée des résultats. Des appels à projets spécifiquement dédiés à la santé des femmes émergent, visant à rattraper le retard accumulé. En France, des rapports parlementaires ont mis en lumière la nécessité d’intégrer la dimension de genre dans les politiques de santé publique et la formation des professionnels. C’est une prise de conscience tardive, mais essentielle, qui marque le début d’une transition vers une médecine plus équitable et personnalisée.
La technologie et l’IA : catalyseurs d’une révolution inattendue ?
Face à ce constat historique, l’espoir d’un changement radical pourrait venir du monde de la technologie. L’intelligence artificielle (IA) et les mégadonnées (big data) offrent des outils sans précédent pour analyser d’immenses volumes de données médicales, identifier des schémas de maladies spécifiques aux femmes, et même prédire des risques avec une précision inédite. Des applications de suivi de cycle menstruel aux dispositifs connectés mesurant des biomarqueurs spécifiques, la « technologie féminine » (femtech) connaît un essor fulgurant. Ces innovations permettent de collecter des informations précieuses et hyper-personnalisées, de pallier le manque de données historiques et de contribuer à la création de diagnostics et de traitements plus ciblés. Si elle est utilisée de manière éthique et inclusive, l’IA pourrait devenir le moteur d’une révolution dans la compréhension et la prise en charge de la santé féminine.
Vers une médecine de précision et une approche genre intégrée
L’avenir de la santé doit impérativement s’orienter vers une médecine de précision qui intègre pleinement la dimension du genre comme variable biologique fondamentale. Cela implique non seulement d’inclure les femmes dans toutes les étapes de la recherche, mais aussi de former les professionnels de santé aux spécificités féminines et de repenser les protocoles de diagnostic et de traitement. La collaboration entre la recherche fondamentale, la médecine clinique et les acteurs de l’innovation technologique est cruciale. C’est en déconstruisant les biais passés et en adoptant une approche holistique et inclusive que nous pourrons enfin garantir une égalité réelle en matière de santé pour toutes et tous, femmes et hommes.
Mots-clés : Santé des femmes, Inégalités de genre, Recherche biomédicale, IA santé, Femtech
Source : Article original
